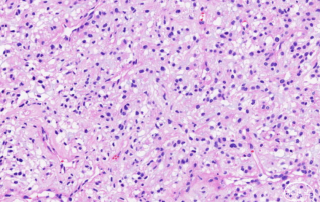
十大滚球体育app

【阔然开朗】下一代病理,阔然生物的中枢神经系统肿瘤微环境整体解决方案
中枢神经系统(CNS)肿瘤包含多种肿瘤类型及其相关亚型,部分肿瘤具有相当高的死亡率和发病率。传统的CNS肿瘤诊断主要基于组织学特征以及与假定的起源细胞类型的相似性。近些年来,随着下一代病理技术和分子生物学的发展,越来越多的研究发现,肿瘤免疫微环境已成为中枢神经系统肿瘤的一个重要方面,可能影响其恶性程度、预后和对治疗的反应。 目前,肿瘤微环境研究所用到的分析方法大多拘泥于单独的免疫组化方法,不能同时识别多个标志物,更难以准确分析肿瘤细胞和间质的异质性与演进规律,对于直接影响疗效的肿瘤微环境缺乏诊断方案。 随着蛋白质组学和多重蛋白原位标记测定技术推向应用,以多重荧光免疫组化(mIHC)技术为代表的下一代病理(NGP)技术能够一次检测多个目标靶点,并通过靶点组合和位置关系的研究,实现更准确、更全面、更高效地评估肿瘤免疫微环境,为肿瘤的诊断和免疫治疗提供了可靠依据。 在业内,下一代病理又被称为继NGS之后,病理科的下一个增量窗口。基于当前下一代病理还处于发展早期,行业对于下一代病理技术及产业的认识还不够深,本文将对下一代病理的产业链生态进行详细解析,期望为行业提供参考。 近年来在脑肿瘤研究领域中应用多重荧光免疫组化技术(mIHC)阐述肿瘤微环境的也逐年增长。2023年发表文章汇总如下: 胶质母细胞瘤(GBM)是侵袭性和致死性的脑肿瘤,尽管有手术切除、放疗和化疗等联合治疗策略,但患者结局较差。GBM患者对免疫治疗不敏感,患者预后较差,中位总生存期(OS)约为21个月。 案例1:新靶标的发现可预测PD-1阻断治疗的患者生存期 在胶质母细胞瘤复发(rGBM)的患者队列中,ERK1/2磷酸化(p-ERK)的免疫组织化学可以预测PD-1阻断后的总生存率,接受PD-1阻断治疗的高p-ERK肿瘤患者表现出更长的生存期。空间距离分析发现,与低p-ERK相比,TMEM119+细胞在高p-ERK肿瘤中更接近SOX2+p-ERK+细胞、CD163+细胞与SOX2+p-ERK+或GFAP+p-ERK+细胞之间的距离更短。 研究结果表明,p-ERK1/2指示rGBM患者对PD-1阻断的反应,rGBM患者拥有由表达MHC II的髓系/小胶质细胞组成的独特肿瘤免疫微环境。这为GBM提供了一个应用个性化方法的免疫治疗的机会,为一部分患者提供治疗益处,同时避免对其他人进行无效治疗。 案例2:单细胞转录组学联合mIHC分析肺腺癌脑转移的肿瘤微环境差异通过肺腺癌的原发肿瘤和脑转移的scRNA、免疫组织化学和免疫荧光揭示原发和转移肿瘤之间巨噬细胞和T细胞的差异,结果显示脑转移上皮细胞(BMAECs,表面生物标志物S100A9)与转移和预后有很强的相关性,结合医院已有样本进一步评估了脑转移指数的临床意义,确定了包括拉帕替尼在内的7种药物通过靶向BMAEC可能抑制LUAD脑转移。本研究分析了scRNA-seq数据,以表征易转移的LUAD病变的免疫微环境。还发现了一个细胞亚群BMAECs及其潜在的生物标志物S100A9,本研究为脑转移高危患者的早期发现和指导潜在治疗提供了见解,并预测了可能对高转移倾向患者有效的治疗药物,为今后进一步开展相关临床研究奠定了基础。 案例3:AAV-LIGHT法可促进胶质瘤的抗肿瘤免疫该研究使用脑内皮细胞靶向腺相关病毒(AAV)载体在小鼠GBM的脉管系统中表达LIGHT(AAV-LIGHT)。使用七色多重荧光免疫组化技术(Panel组成:CD8、CD4、CD19、TCF1、CD11c、CD31、Nuclei)分析发现在AAV-LIGHT组中,TLS和肿瘤内均存在TCF1+ CD8+ T细胞,而且更常聚集到与CD11c+ DC(抗原呈递)密切相互作用的微环境中,并定位于类似HEV的CD31+血管附近。该研究表明,通过靶向表达LIGHT来改变血管表型可以促进有效的抗肿瘤T细胞反应并延长胶质瘤的生存期,是一种有希望的GBMs治疗选择,包括那些对检查点阻断无反应的GBMs,这些发现对其他免疫治疗耐药癌症的治疗具有更广泛的意义。2023年4月,由北京市希思科临床肿瘤学研究基金会、良医汇和研值圈联合主办的“第三届肿瘤黑科技年会”,阔然生物凭借下一代病理技术(NGP)荣获“最受关注的肿瘤黑科技奖”。该项目基于多重荧光免疫组化技术,开发了成人胶质瘤分子分型AI判断系统,通过检测与胶质瘤分型及预后相关的6个重要指标,从单细胞水平的量化结果实现更细亚群的分层,更精准地评估胶质瘤患者的预后。通过更加精准、全面的预后评估,对于患者个性化用药诊疗、随访及疾病控制等方面具有重要的临床价值。 下一代病理技术已日趋完善, 产业化命题亟待解答 病理诊断在精准医学中扮演着非常重要的角色,面对不断精细的临床诊断需求,病理检查能够为手术、随访、用药、化疗的临床决策提供关键信息。但长期以来,由于流程繁琐,自动化程度较低,病理医生缺乏等原因,我国的病理学建设程度较低。 随着精准医疗的持续推进,民众生活水平不断提高,人们对于各类型疾病筛查的病理诊断需求逐年上升,病理诊断供需矛盾突出。 在此背景下,以多重荧光免疫组化(mIHC)技术为核心的下一代病理逐渐受到关注。
【阔然开朗】IDH1 突变抑制剂 DS-1001 在复发性或进展性 IDH1 突变神经胶质瘤患者中的首次人体 I 期研究
胶质瘤是颅内最常见的恶性肿瘤,目前主要治疗方案是放疗和化疗,但是疗效有限,特别是在高级别胶质瘤中。这也进一步表明探索胶质瘤新的治疗方案的重要性。IDH基因是目前药物研究热点,IDH 抑制剂包括 ivosidenib(AG-120)、vorasidenib(AG -881)、olutasidenib (FT-2102)、BAY1436032等都处于临床试验中。目前正在针对神经胶质瘤患者的临床试验中进行评估。在临床前研究中,DS-1001 已被证明可以抑制突变 IDH1,从而降低 D-2-HG 水平和肿瘤大小。本研究评估IDH抑制剂 DS-1001 药物对复发/进行性 IDH1 突变胶质瘤患者疗效和药效分析。 共入组47名患者(少突胶质细胞瘤 WHO 2级:少突胶质细胞瘤 WHO 3级:星形细胞瘤WHO 2级:星形细胞瘤WHO 3级:星形细胞瘤WHO
【阔然开朗】p16 蛋白表达缺失是高级别脑膜瘤中CDKN2A基因纯合缺失标志物
脑膜瘤是颅内最常见的良性肿瘤,其中WHO I级脑膜瘤占80%。现在关于脑膜瘤基因组分析研究发现与传统的肿瘤细胞形态学评估相比,分子标志物可以更好地预测患者的预后。研究表明无论组织学级别,携带CDKN2A纯合缺失或TERT启动子突变的脑膜瘤患者的临床预后与组织学诊断为间变性脑膜瘤(CNS WHO 3 级)的患者相似。因此,2021 年 WHO 中枢神经系统肿瘤分类中对间变性脑膜瘤的诊断特征包括TERT启动子突变或CDKN2A纯合缺失。但对于脑膜瘤的分子标志物检测平台暂时没有相关推荐。研究发现在脑膜瘤中存在 p16 蛋白表达缺失,但与CDKN2A基因之间的相关性暂时没有报道。 为了探索p16蛋白和CDKN2A基因之间的相关性,入组了 39 个高级别的脑膜瘤患者:非典型(2级,n=27,69%)、间变性(3级,n=12,31%)。利用DNA NGS测序分析CDKN2A基因的突变和拷贝数变异,利用免疫组化检测p16蛋白的表达。 DNA NGS结果显示7个脑膜瘤患者存在CDKN2A纯合缺失。免疫组化显示肿瘤细胞中p16蛋白表达缺失,在非肿瘤内皮细胞和炎症细胞中p16具有完整的染色。一个脑膜瘤患者(病例 #43)NGS结果显示CDKN2A 基因发生p.A60fs 失活截短突变,免疫组化显示肿瘤细胞中p16蛋白表达缺失。在31名NGS结果显示CDKN2A没有发生突变脑膜瘤中,28名患者免疫组化提示p16蛋白表达,但存在3名患者(病例 #5、#6和
【阔然开朗】分子病理下脑膜瘤的治疗
声明:脑医汇旗下神外资讯、神介资讯、神内资讯、脑医咨询、AiBrain 所发表内容之知识产权为脑医汇及主办方、原作者等相关权利人所有。 投稿邮箱:[email protected] 未经许可,禁止进行转载、摘编、复制、裁切、录制等。经许可授权使用,亦须注明来源。欢迎转发、分享。
【阔然开朗】DNA甲基化图谱分类中少突胶质肉瘤亚型可能包括IDH野生型胶质瘤
少突胶质肉瘤是一类特殊的少突胶质细胞瘤,需要结合肉瘤组织学特征、IDH突变、TERT启动子突变或1p/19q发生共缺失这3个特征综合诊断,在一些无法进行明确诊断的案例中建议使用DNA甲基化图谱进行诊断。 本文介绍一例罕见的复发性 IDH野生型的成人胶质瘤,患者在1988年出现右侧额叶病变,进行粒子植入术治疗,后进行手术切除肿瘤组织,病理诊断为弥漫性星形细胞瘤;2021年7月出现复发,进行手术切除,组织学病理显示肉瘤样特征、栅栏状坏死区域、微血管增生和丰富的核分裂;免疫组化结果显示Olig2和GFAP阴性,MAP2C和YAP1表达阳性,H3K27me3表达弱阳性,IDH1(p.R132H)表达阳性、ATRX表达阳性。NGS测序结果显示TERT启动子突变、TP53无义突变、CIC突变,多个染色体出现拷贝数变异;RNA测序结果显示未发现基因融合。未发现与IDH野生型的胶质肉瘤/胶质母细胞瘤相关的典型基因突变,如EGFR、MET、PDGFRA等。DNA甲基化图谱结果显示IDH突变型的少突胶质肉瘤(脑肿瘤分类 12.5版)。 目前对于少突胶质肉瘤相关的报道较少,大部分报道的案例显示可能是原发性少突胶质细胞瘤复发导致,分子特征是IDH发生突变,1p/19q可能出现共缺失。本案例无法回溯1988年组织样本中的IDH变异情况,复发样本显示IDH野生型、多个染色体发生拷贝数变异,如7号染色体扩增、10号染色体缺失、CDKN2A/B纯合缺失,这些特征多出现在胶质肉瘤/胶质母细胞瘤中,但文献报道放疗复发的胶质肉瘤/胶质母细胞瘤大多没有TERT启动子突变和Chr7+/10-的分子特征。有文章报道原发性胶质瘤在放疗后会出现IDH突变“丢失”,这种丢失是由于突变等位基因缺失,本案例中的2号染色体(IDH1基因所处染色体)和15号染色体(IDH2基因所处染色体)的缺失可能是IDH野生型的原因。 本文报道了一名罕见复发胶质瘤患者,NGS测序结果显示IDH野生型但出现胶质肉瘤/胶质母细胞瘤中常见拷贝数变异如Chr7+/10-、CDKN2A纯合缺失。但DNA甲基化测序诊断为少突胶质肉瘤 IDH突变型。这为少突胶质肉瘤的诊断提供新证据。 参考文献Ebrahimi A, Herrlinger U, Waha A, Kaluza L, Pietsch T. Methylation class oligosarcoma
脑膜瘤基因检测助力脑膜瘤患者临床诊疗
脑膜瘤是中枢神经系统常见的肿瘤,根据组织形态将脑膜瘤分为15种亚型。基于组织学的脑膜瘤分级系统难以精准预测肿瘤的生物学行为,为诊治带来一定的挑战。此外,一些脑膜瘤与颅内间叶性肿瘤形态类似,且缺乏特异性诊断标记物,鉴别诊断困难。第5版WHO中枢神经系统肿瘤分类首次将分子特征纳入脑膜瘤分类,使脑膜瘤的诊断、分型及分级更加精确。今天,宁波市临床病理诊断中心葛荣主任医师分享一例诊断和分级困难的脑膜瘤病例,通过阔然基因脑膜瘤分子分型检测和融合基因检测项目对患者检测,辅助患者病理诊断,并进一步为临床治疗提供决策。 病例概况 患者,男,41岁。一月前无明显诱因出现头痛,查头颅MRI提示右侧桥小脑角区占位,脑膜瘤考虑(图1)。行后颅窝肿瘤切除,术后送检组织灰白灰褐色一堆,大小4.5×4.5×0.6cm。组织学:瘤细胞形态一致,卵圆形,间质黏液变(图2)。免疫组化:Vimentin(+++)、EMA(小灶+)、PR(-)、Ki-67(+)5%、P53(-)、GFAP(-)、NSE(-)、Olig2(-)、CgA(-)、Syn(-)、S-100(-)、CD31(-)。病理诊断:(后颅窝肿瘤)脑膜瘤,WHO 1级。术后患者按照WHO 1级脑膜瘤随访。 右侧桥小脑角区可见团块状稍长T1稍长T2信号影,DWI未见明显受限,周围可见脑组织水肿,范围约37mm*22mm*34mm,界尚清,增强呈明显均匀强化,可见脑膜尾征,相应骨质增厚,相应小脑及脑干受压,第四脑室受压。 两年后,患者查头颅MRI提示右侧桥小脑角区脑膜瘤术后,考虑脑膜瘤复发、侵袭可能(图3)。行颅底肿瘤切除,术中肿瘤广泛侵犯乳突骨皮质、硬膜及小脑,延颅底骨质侵犯至颈静脉孔及破裂孔,包绕颈内动脉,肿瘤灰红色,质地韧,血供极其丰富。 术后送检病理,灰白灰红碎组织一堆,总积3×3×1.5cm。组织学:纤维硬化性间质中见多量上皮样小圆细胞浸润,局部间质黏液变(图4),缺乏常见脑膜瘤的形态。免疫组化:MUC-4(弥漫+),CD99(+),Vimentin(+),Fli-1(+),EMA(小灶+),SSTR2(小灶+),PR(-),Desmin(-),CK(pan)(少量+),Syn(灶+),GATA-3(灶+),Ki-67(+3%),,H3K27Me3(+),INI-1(+),CAM5.2(-),PAX-8(-),SOX-10(-),S-100(-),CD31(-),CD34(-),CK5/6(-),GFAP(-),Olig2(-),Calponin(-),SMA(-),STAT6(-),SATB2(-),NKX2.2(-),CD138(-),Wilms Tumor(-)。病理诊断:考虑颅内软组织肿瘤,倾向1.低级别纤维黏液样肉瘤;2.FET-CREB融合阳性的颅内间叶性肿瘤,建议做二代测序分子检测明确。 患者样本通过阔然基因脑膜瘤分子分型检测和融合基因检测项目检测。结果显示,患者肿瘤组织检测出22q缺失、1p、14q缺失(图3)和AP3S2-RWDD2B融合(尚未见文献报道);未检出低级别纤维黏液样肉瘤特异性FUS-CREB3L2融合和颅内间叶性肿瘤FET-CREB家族相关性融合。 根据分子检测结果,患者被确诊为脑膜瘤,分子分型是MC int-A型,同时检出1p/14q染色体缺失,与不良预后和复发风险增加相关,辅助临床解释为何该患者短期复发。